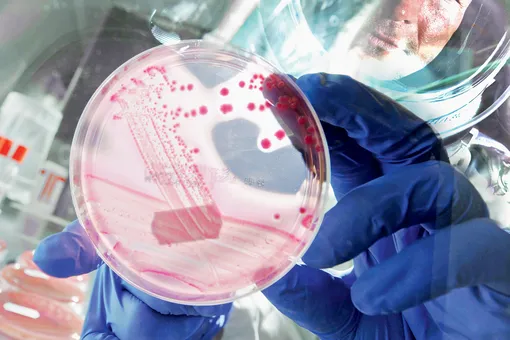

Математика и Космос: Личный Опыт и Открытия
Эффект Ярковского: Невидимый Дирижер Астероидных Танцев Представьте себе бескрайний космос, где миллионы астероидов, словно космические странники, бороздят
Аэроторможение: Как Космические Корабли Замедляют Свой Бег у Других Планет Когда мы смотрим на фотографии, присланные марсоходами или аппаратами, исследующими
Эффект реактивного торможения: Как мы покоряли космос‚ не сжигая топливо Космос… бескрайние просторы‚ манящие своей загадочностью и недоступностью.
Эффект реактивного торможения (Aerobraking): Как мы покоряли космос, экономя топливо Приветствую, друзья! Сегодня мы хотим поделиться с вами захватывающей
Реактивное Торможение: Как Космические Аппараты Используют Атмосферу для Экономии Топлива Приветствую, дорогие читатели! Сегодня мы погрузимся в захватывающий
Эффект реактивного торможения: Как мы покоряли космос, экономя топливо Космос… Бескрайний, манящий, но и невероятно требовательный к ресурсам.
Эффект реактивного торможения: Как мы покоряли космос, экономя топливо В мире космических путешествий, где каждый грамм топлива на счету, а каждая секунда
Эффект реактивного торможения: Как мы покоряли космос, экономя топливо В мире космических путешествий, где каждый грамм топлива на счету, а каждая секунда
Как Космический "Парашют" Спасает Миллионы: Наш Опыт Аэроторможения Привет, друзья! Сегодня мы хотим поделиться с вами захватывающим опытом
Как Космический "Парашют" Спасает Миллионы: Наш Опыт Аэроторможения Привет, друзья! Сегодня мы хотим поделиться с вами захватывающим опытом